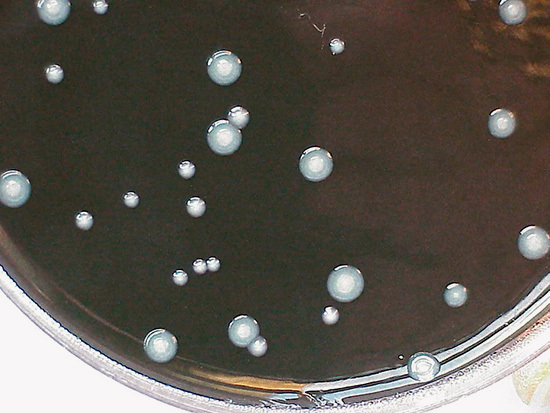
Auf einem Nährboden können sich kleine, zählbare Kolonien von Legionellen 
bilden die so genannten KBE

Systemische Untersuchungen von TrinkwasserInstallationen
Seitdem die Trinkwasserverordnung eine Untersuchung von Legionellen in bestimmten TrinkwasserInstallationen vorschreibt, ruft dies einige Aktivitäten auf den Plan.

Der SBZ Monteur wird ein wenig Licht in diese sonst eher unbekannte Welt der Probenahme bringen. Wer will da wo untersuchen? Und wie zählt man aus, ob die Legionellen in nennenswerter Stückzahl auftreten? Ein Blick über den Tellerrand zu den Weißkitteln ins Labor schließt sich daher auch noch an.
Zweck der Untersuchung
In jedem Trinkwassersystem sind Legionellen vorhanden, das kann man getrost unterstellen. Aber erst wenn diese in größeren Gruppen auftreten können Sie dem Menschen unter gewissen Umständen gefährlich werden. Nimmt man nämlich größere Mengen Legionellen aus fein verdüsten Wassertröpfchen auf, so kann dies zur Erkrankung führen. Fein verdüste Wassertropfen, so genannte Aerosole, entstehen beispielsweise beim Duschen. Immungeschwächte, also erkrankte Menschen können durch die Aufnahme dieser befallenen Aerosole im schlimmsten Fal zu Tode kommen.
Grund genug für unsere Gesundheitsämter diese gefährliche Anhäufung von Legionellen untersuchen zu lassen.
Für Legionellen wird daher ein technischer Maßnahmenwert benannt. Dieser liegt bei 100 Koloniebildenden Einheiten je 100 Milliliter Wasser. (100 KBE/100 ml). Bei Überschreitung kann das Gesundheitsamt eine Ortsbesichtigung der betroffenen Trinkwasserinstallation und eine Gefährdungsanalyse vorschreiben. Die Überschreitung des technischen Maßnahmewertes bedeutet aber nicht gleichzeitig, dass eine Gesundheitsgefährdung vorliegt.

Wer darf Proben nehmen?
Für das Gesundheitsamt dürfen Labore des Vertrauens diese Proben erstellen und untersuchen. Sie werden daher als akkreditierte Labore bezeichnet. Die Labore dürfen sich aber auch entsprechend geschultes Personal zur Hilfe holen. Das jeweilige Labor trägt die Verantwortung bezüglich Qualifikation dieser Helfer. Die Verantwortung dieses Personenkreises ist entsprechend hoch. Denn eine falsche Probenahme und insbesondere die Handhabung der Proben können das Bild von der Gefährdung stark verzerren.
Wo wird gesucht?
Natürlich könnte man in einen 20 Jahre alten und entleerten Trinkwassererwärmer krabbeln und in einer verwinkelten Ecke einen Schluck Restwasser mittels Putzlappen in ein Probefläschchen wringen. Der Maßnahmewert wäre unter solchen Bedingungen sicherlich häufig überschritten. Aber das Auffinden punktueller Spitzenwerte ist nicht das Ziel. Zwei klassische Probenahmestellen eines Netzes sind aber tatsächlich am Trinkwassererwärmer angelegt. Dort nämlich, wo das warme Wasser austritt und später über die Zirkulation wieder eintritt ist eine Probe zu nehmen. Entsprechende Probenahmestellen sind dafür einzurichten. Weitere Entnahmen sollten in Bereichen mit möglicher Vernebelung von Trinkwasser führen. Das bedeutet, dass in einem Mehrfamilienhaus mit Duschmöglichkeiten in den Wohnungen Proben vorgenommen werden. Dabei kommt nicht zwingend jede Wohnung auf die Fahndungsliste. Es reicht erstmal die kritischen Wohnungen zu betrachten. Das sind regelmäßig jene, die am weitesten entfernt vom Trinkwassererwärmer gelegen sind. Lange Wege bedeuten nämlich eine Abnahme der Temperatur des fließenden Zirkulationswassers. Und milde Temperaturen, unter 55 °C begünstigen Legionellenwachstum.
Eine Waschtischarmatur in einer solchen, entfernten Wohnung mit Duschmöglichkeit ist dafür geeignet.

Wie die Probe ziehen?
Egal, ob direkt am Trinkwassererwärmer oder in der entfernteren Umgebung gilt es bestimmte Schritte zur Probenahme einzuhalten.
Schritte der Probennahme
1. Vorbereitung der Entnahmestelle:
Entfernen von Strahlreglern und anderen Vorrichtungen und Desinfektion der Auslaufstelle
2. Spülung der Entnahmearmatur:
Öffnen der Entnahmearmatur, Ablauf von 1 Liter Trinkwasser in einen Messbecher und Verwerfen des Wassers
3. Befüllen des Probenbehälters:
Direkt anschließend (ohne Schließen und erneutes Wiederöffnen der Entnahmearmatur)
Trinkwasser in einen sterilen Probenbehälter abfüllen und diesen verschließen
4. Messung der Temperatur bei der Probennahme:
Direkt anschließend weitere ca. 250 ml Trinkwasser in einen Messbecher abfüllen und die Wassertemperatur unverzüglich messen und dokumentieren als so genannte „Probennahmetemperatur“.
5. Messung der Wassertemperatur bei Temperaturkonstanz:
Trinkwasser aus der Entnahmearmatur bis zur Temperaturkonstanz in einen Messbecher ablaufen lassen und in dem Messbecher die Wassertemperatur messen. Die Temperatur ist ebenfalls zu dokumentieren als die „Konstante Temperatur“.
Dabei ist wegen der möglichen Verunreinigung der Entnahmearmaturen eine gründliche Reinigung notwendig. Daher soll entweder mittels einer Flamme oder desinfizierendem Alkohol diese Armatur gewissermaßen entkeimt werden.
Dokumentation
Jede Probenahme wird dokumentiert mit den wesentlichen Stichpunkten, die für eine anschließende Auswertung interessant sein können.
Doku der Probennahme
- Name und Art des Gebäudes (z.B. Krankenhaus, Sporteinrichtung, Pflegeeinrichtung, Wohngebäude, vermietete Betriebsstätte)
- Bezeichnung des Gebäudeteils (z.B. Bauabschnitt, Stockwerk / Etage, Funktionsbereich und Raum)
- Lokale Lage der Entnahmestelle (z.B. Strang, Verteiler, Waschtisch, Spüle, Wanne, Dusche)
- Art der Entnahmestelle (z.B. Entleerungsventil, Kugelhähne, EinhebelMischarmatur, ZweigriffMischarmatur, Armatur mit Verbrühungsschutz)
- Angaben zum Trinkwasser (z.B. erwärmtes Trinkwasser, gemischtes Trinkwasser, kaltes Trinkwasser)
Transport der Probe
Würde eine korrekt erstellte Probe anschließend mehrere Tage in einem überhitzten Fahrzeug durch die Gegend gefahren, würde dies die anschließende Untersuchung sicherlich verfälschen. Die Proben sollten natürlich am gleichen Tag ins Labor, spätestens nach zwei Tagen. Dabei sind diese in jedem Fall lichtgeschützt zu transportieren. Eine Kühlung auf 5 °C ist einzuhalten, wenn die Proben nicht mehr am Tage der Probenahme das Labor erreichen.
Untersuchung der Probe
Im Labor werden zwei wesentliche Untersuchungsmethoden angewandt. Die eine wird als Direktansatz bezeichnet.
Dabei wird von dem Probenwasser zweimal 0,5 Milliliter auf ein Schälchen geträufelt und verrieben. Auf dem Schälchen befindet sich ein Nährboden für eventuelle Legionellen. Befinden sich also Legionellen in einem jeweiligen Tropfen, so beginnen sie zu wachsen, bilden gewissermaßen eine Kolonie. Diese zählt man dann nach einer gewissen Wachstumszeit aus, da diese dann sichtbare Flecken auf dem Nährboden hinterlassen.
Beispiel: Eine Platte aus diesem Direktansatz enthält 3 Kolonien, die zweite Platte enthält eine Kolonie. Ergebnis: 1 ml Probe enthalten 4 Kolonien; es wurden 400 KBE pro 100 ml gefunden.
Eine weitere Untersuchungsmethode ist ebenso clever. Man lässt eine definierte Probenmenge durch eine Membrane laufen. Diese Membrane ist wie ein äußerst feinmaschiger Filter und hält eventuell vorhandene Legionellen zurück. Anschließend sorgt man wiederum für eine Koloniebildung auf dieser Membranplatte um die winzigen Legionellen sichtbar zu machen. Man zählt dann die sichtbaren Häufchen aus und erstellt ebenfalls eine Hochrechnung.
Beispiel: Platte nach Filtration von 10 ml Probe enthält 7 Kolonien, Platte nach Filtration von 100 ml enthält 115 Kolonien. Ergebnis: 110 ml Probe enthalten die Summe von 122 Kolonien; es wurden 111 KBE pro 100 ml gefunden.
Zusammenfassung
Diese Kenntnisse über die systemische Untersuchung von Trinkwasser machen einen noch nicht zum akkreditierten Probenehmer. Aber das Wissen über die Zusammenhänge hilft bei der Einschätzung dieses, für das Sanitärhandwerk, wichtigen Hygieneziels. Der Anlagenmechaniker wird zumindest mit den Probenahmestellen von größeren Trinkwasserinstallationen konfrontiert. Wer weitere Details erfahren möchte kann auf www.umweltbundesamt.de die Empfehlungen zur Probennahme kostenfrei herunterladen. Einige Textstellen dieses Berichts enthalten bereits Hinweise der Empfehlungen des Bundesamtes.






